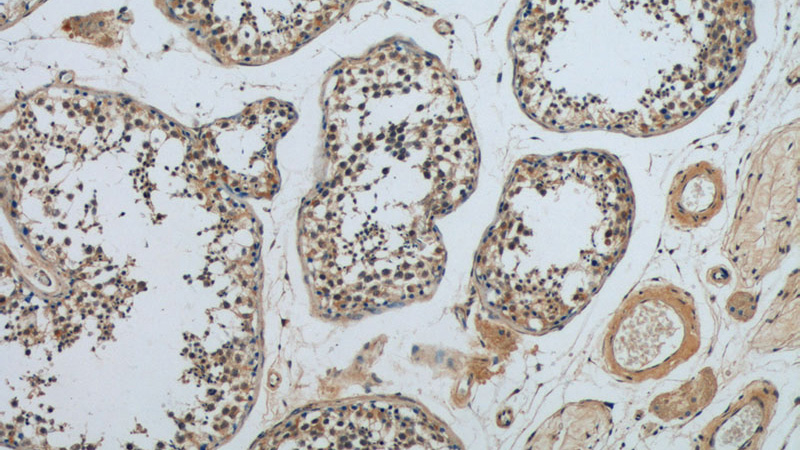
Immunohistochemistry of paraffin-embedded human testis tissue slide using Catalog No:108372(BBS5 Antibody) at dilution of 1:50 (under 10x lens)
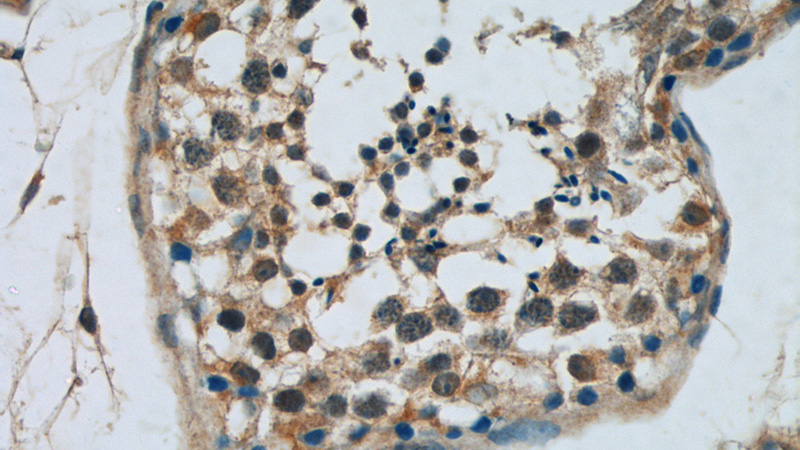
Immunohistochemistry of paraffin-embedded human testis tissue slide using Catalog No:108372(BBS5 Antibody) at dilution of 1:50 (under 40x lens)

-
Product Name
BBS5 antibody
- Documents
-
Description
BBS5 Rabbit Polyclonal antibody. Positive IHC detected in human testis tissue, human stomach tissue. Positive IF detected in hTERT-RPE1 cells. Positive IP detected in mouse testis tissue. Positive WB detected in mouse testis tissue, human testis tissue, rat testis tissue. Observed molecular weight by Western-blot: 40-45 kDa
-
Tested applications
ELISA, WB, IF, IHC, IP
-
Species reactivity
Human,Mouse,Rat; other species not tested.
-
Alternative names
Bardet Biedl syndrome 5 antibody; BBS5 antibody
-
Isotype
Rabbit IgG
-
Preparation
This antibody was obtained by immunization of BBS5 recombinant protein (Accession Number: NM_152384). Purification method: Antigen affinity purified.
-
Clonality
Polyclonal
-
Formulation
PBS with 0.02% sodium azide and 50% glycerol pH 7.3.
-
Storage instructions
Store at -20℃. DO NOT ALIQUOT
-
Applications
Recommended Dilution:
WB: 1:200-1:1000
IP: 1:200-1:2000
IHC: 1:20-1:200
IF: 1:10-1:100
-
Validations

IF result from Dr. Corbit, Kevin. anti-BBS5(Catalog No:108372) marks the ciliary membrane and basal bodies of Human hTERT-RPE1 cells.

mouse testis tissue were subjected to SDS PAGE followed by western blot with Catalog No:108372(BBS5 antibody) at dilution of 1:400

IP Result of anti-BBS5 (IP:Catalog No:108372, 3ug; Detection:Catalog No:108372 1:500) with mouse testis tissue lysate 2800ug.
Immunohistochemistry of paraffin-embedded human testis tissue slide using Catalog No:108372(BBS5 Antibody) at dilution of 1:50 (under 10x lens)
Immunohistochemistry of paraffin-embedded human testis tissue slide using Catalog No:108372(BBS5 Antibody) at dilution of 1:50 (under 40x lens)
-
Background
BBS5 encodes a protein that has been directly linked to Bardet-Biedl syndrome. Bardet-Biedl syndrome (BBS) is an autosomal recessive condition characterised by rod-cone dystrophy, postaxial polydactyly, central obesity, mental retardation, hypogonadism, and renal dysfunction. Other associated clinical findings in BBS patients include diabetes, hypertension and congenital heart defects. BBS expression varies both within and between families and diagnosis is often difficult. Experimentation in non-human eukaryotes suggests that BBS5 is expressed in ciliated cells and that it is required for the formation of cilia. Alternate transcriptional splice variants have been observed but have not been fully characterized.
-
References
- Barbelanne M, Hossain D, Chan DP, Peränen J, Tsang WY. Nephrocystin proteins NPHP5 and Cep290 regulate BBSome integrity, ciliary trafficking and cargo delivery. Human molecular genetics. 24(8):2185-200. 2015.
- Siller SS, Burke MC, Li FQ, Takemaru K. Chibby functions to preserve normal ciliary morphology through the regulation of intraflagellar transport in airway ciliated cells. Cell cycle (Georgetown, Tex.). 14(19):3163-72. 2015.
- Raman M, Sergeev M, Garnaas M. Systematic proteomics of the VCP-UBXD adaptor network identifies a role for UBXN10 in regulating ciliogenesis. Nature cell biology. 17(10):1356-69. 2015.
- Jin H, White SR, Shida T. The conserved Bardet-Biedl syndrome proteins assemble a coat that traffics membrane proteins to cilia. Cell. 141(7):1208-19. 2010.
- Garcia-Gonzalo FR, Corbit KC, Sirerol-Piquer MS. A transition zone complex regulates mammalian ciliogenesis and ciliary membrane composition. Nature genetics. 43(8):776-84. 2011.
- Smith TS, Spitzbarth B, Li J. Light-dependent phosphorylation of Bardet-Biedl syndrome 5 in photoreceptor cells modulates its interaction with arrestin1. Cellular and molecular life sciences : CMLS. 70(23):4603-16. 2013.
- Chamling X, Seo S, Searby CC, Kim G, Slusarski DC, Sheffield VC. The centriolar satellite protein AZI1 interacts with BBS4 and regulates ciliary trafficking of the BBSome. PLoS genetics. 10(2):e1004083. 2014.
- Sinha S, Belcastro M, Datta P, Seo S, Sokolov M. Essential role of the chaperonin CCT in rod outer segment biogenesis. Investigative ophthalmology & visual science. 55(6):3775-85. 2014.
Related Products / Services
Please note: All products are "FOR RESEARCH USE ONLY AND ARE NOT INTENDED FOR DIAGNOSTIC OR THERAPEUTIC USE"
